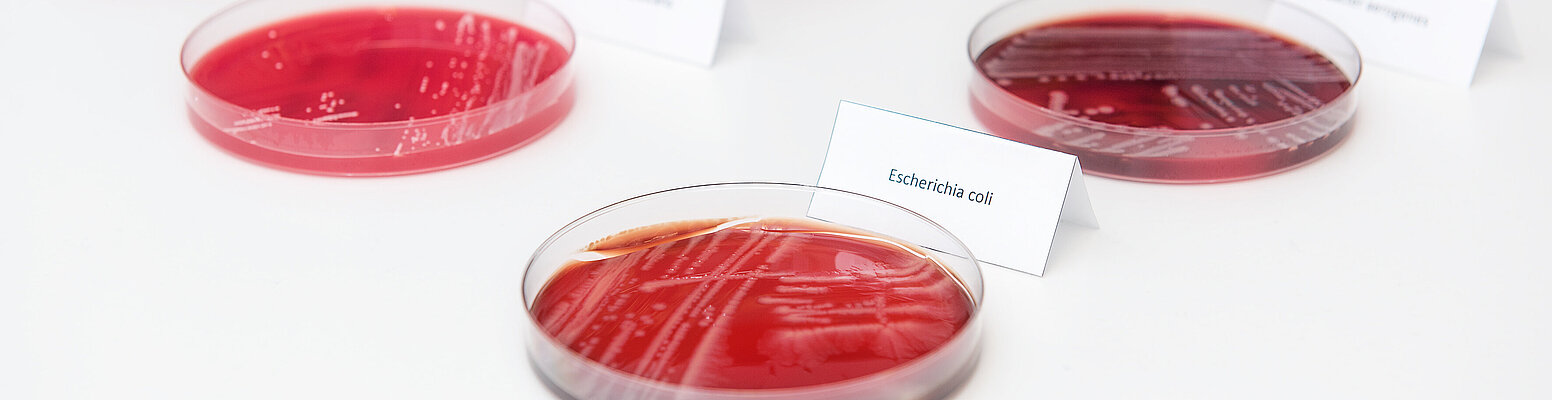

Curriculum „Antibiotic Stewardship (ABS)“
Rationale Antibiotikatherapie im Krankenhaus
Liebe Kolleginnen und Kollegen,
wir laden Sie sehr herzlich zum Grundkurs zum ABS-beauftragten Arzt (40 Stunden) gemäß dem Curriculum der Bundesärztekammer ein.
Ort: Hörsaal 4, Haus 6, Universitätsklinikum Halle (Saale)
Termin: 16.03. bis 20.03.2026
Anmeldungen:
Teilnahmegebühr: keine
Teilnehmen kann jeder am UKH tätige Arzt.
Die Anmeldung kann formlos per E-Mail erfolgen - bitte wenden Sie sich an:
infektiologie@uk-halle.de
Die Anmeldefrist endet am 1. März 2026.
Wir freuen uns, Sie zum diesjährigen ABS-Kurs begrüßen zu dürfen.
Download: